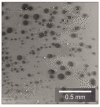
Figure 13

Determination of Suitable Imaging Techniques for the Investigation of the Bonding Zones of Asphalt Layers
- PMID: 34947154
- PMCID: PMC8705704
- DOI: 10.3390/ma14247556
Determination of Suitable Imaging Techniques for the Investigation of the Bonding Zones of Asphalt Layers
Abstract
The material behavior of asphalt depends on its composition of aggregate, bitumen, and air voids. Asphalt pavements consist of multiple layers, making the interaction of the materials at the layer boundary important so that any stresses that occur can be relieved. The material behavior at the layer boundary is not yet understood in detail, as further methods of analysis are lacking in addition to mechanical methods. For this reason, the layer boundary of asphalt structures was analyzed using imaging methods. The aim of this research was to find an imaging method that allows a detailed analysis of the bonding zone of asphalt layers. Two different imaging techniques were used for this purpose. One is a 2-D imaging technique (asphalt petrology) and the other is a 3-D imaging technique (high-resolution computed tomography). Image analysis is a widely used technique in materials science that allows to analyze the material behavior and their composition. In this research, attention was paid to the analysis of the position of the bitumen emulsion, because the contained bitumen is supposed to bond the layers together. It was found that the application of 2-D imaging (asphalt petrology) lacked the precision for a detailed analysis of the individual materials at the layer boundary. With high-resolution computed tomography, a detailed view is possible to visualize the individual materials at the layer boundary in 3D. However, it is difficult to differentiate the materials because there are no gradations in the gray values due to the identical densities. However, it is possible to differentiate between the bitumen from the asphalt and from the emulsion if a high-density tracer is added to the bitumen emulsion for the CT studies. The results of the investigations are presented in this article.
Keywords: X-ray computer tomography; asphalt; asphalt petrology; bitumen emulsion; layers bond.
Conflict of interest statement
The authors declare no conflict of interest.
Figures

References
-
- Stöckert U. Ph.D. Thesis. Technische Universität Darmstadt; Darmstadt, Germany: 2002. Ein Beitrag zur Festlegung von Grenzwerten für den Schichtenverbund im Asphaltstraßenbau.
-
- Wistuba M., Wellner F. Zyklische Schersteifigkeits und Scherermüdungsprüfung zur Bewertung und Optimierung des Schichtenverbundes in Straßenbefestigungen aus Asphalt. Forschungsbericht; Technische Universität Dresden; Dresden, Germany: 2016.
-
- Leutner R., Renken P., Lobach T. Auswirkung Unterschiedlicher Verbundsysteme auf die Mechanischen Eigenschaften eines Mehrschichtigen Asphaltpaket. Forschungsbericht; Technische Universität Braunschweig; Braunschweig, Germany: 2004.
-
- Ceccon Carlesso G., Trichês G., Staub de Melo J.V., Marcon M.F., Padilha Thives L., da Luz L.C. Evaluation of Rheological Behavior, Resistance to Permanent Deformation, and Resistance to Fatigue of Asphalt Mixtures Modified with Nanoclay and SBS Polymer. Appl. Sci. 2019;9:2697. doi: 10.3390/app9132697. - DOI
-
- Wen H., Wu S., Mohammad L.N., Zhang W., Shen S., Faheem A. Long-Term Field Rutting and Moisture Susceptibility Performance of Warm-Mix Asphalt Pavement. Transp. Res. Rec. J. Transp. Res. Board. 2016;2575:103–112. doi: 10.3141/2575-11. - DOI
Publication types
LinkOut - more resources
Full Text Sources

